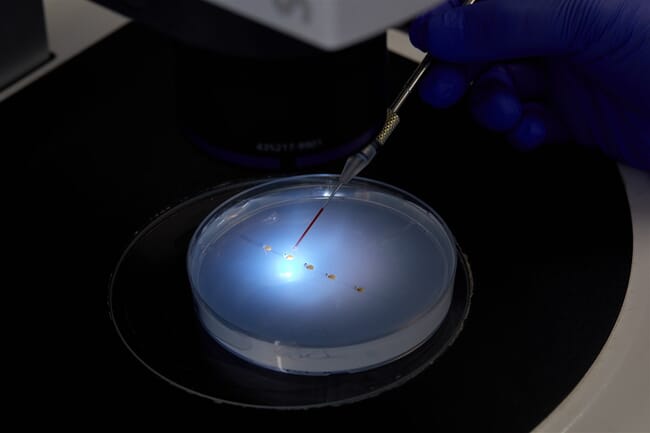
The microinjection process.

© CAT
So champion the team at the Centre for Aquaculture Technologies (CAT) – one of the sector’s leading proponents of genome editing – which has tested the technology to great effect for a number of aquatic species, leading to significant improvements in key traits including rates of growth and feed conversion.
The case for sterility
There are plenty of strong arguments for producing animals that aren’t able to go through sexual maturation – arguments that align with many of the key goals of the aquaculture industry.
“Sexual maturation triggers a whole host of interesting behavioural changes, but some of those are less desirable in a culture setting, reducing performance and efficiency,” notes Dr Debbie Plouffe, vice-president of business development at CAT.
Changes brought about by sexual maturation in some more recently domesticated species include increased levels of aggression, which leads to welfare issues and possible increases in mortalities.
“Not devoting energy to sexual maturation also increases growth rates and, usually, when you have an improvement in growth performance, you have an improvement in FCR as well. This is, of course, very interesting from a commercial perspective, because feed is the most costly input and if you can reduce the amount of feed and produce the same amount of fish it’s a great sustainability story and good for business as well,” Plouffe observes.
There’s also a strong welfare argument, as the energy that’s being devoted to sexual maturation is diverted from the immune system, making mature fish more susceptible to disease. And there’s an important environmental perspective too.
“The fact is that we still grow the cultured animals right next door to the wild animals, but we don’t want the traits that are important for aquaculture and commercial production being transmitted to wild fish, as they may not be the same traits that make wild fish successful,” Plouffe notes.
Meanwhile, there are also strong incentives, when the bigger picture – the role of aquaculture in feeding the planet – is considered, as switching to sterile stocks can help to enhance production efficiency as well as reduce the industry’s environmental impact.
“The underlying motivation relates to food security and the need to feed a global population that's expected to reach 9 billion by mid-century. Aquaculture is going to be a big piece of increasing animal protein production, but as it expands, we need to do it in an environmentally responsible manner. We cannot sit and wait to change the way we're producing food. We have to offer solutions now. Doing nothing is not sustainable,” explains Dr Xavier Lauth, CAT’s director of innovation.
“Starting with sterility as a foundational trait theoretically eliminates concerns about potential environmental impacts and simplifies the regulatory process, making it more reassuring for regulators. We've always said that where genome editing is going to become successful as a technology is when the needs of the producers and the consumers are aligned and everybody wants more sustainable production and better animal welfare. So, if you start with sterility that delivers a lot on its own, then you can start talking about adding in additional traits using genome editing, whether it's disease resistance traits, fillet yield traits, or added nutritional value,” adds Plouffe.

© CAT
Sterilisation techniques
There are a number of options for inducing sterility in farmed aquatic species, but the most common commercial approach is currently triploidisation – a technique that’s widely used in the Pacific oyster sector and, to a lesser extent, in Atlantic salmon too.
“Triploid salmon are produced by applying hydrostatic pressure to newly fertilised eggs. And this creates a fish with three sets of chromosome rather than two. However, these fish are suboptimal when farming conditions are not ideal. They tend to have lower survival during early development and it's been noted that they have different rates of skeletal deformities,” explains Lauth.
Another limitation is that most farming operations do not have access to fertilised eggs, but are reliant on the animals breeding naturally, making triploidy deeply impractical. Moreover, Lauth notes that triploidy is not 100 percent effective at achieving sterility, which means that it is too risky to rely on, especially when genome edited animals are involved.
“We have always drawn that line in the sand: when we are dealing with GE fish, there needs to be 100 percent efficacy. We want to make sure that not a single fish that could potentially escape could breed with the wild population and mix with the wild genetic pool,” Lauth emphasises.
Alternative methods
The production of sterile fish has been a major focus of research for decades, with various solutions proposed beyond triploidy, including non-genetic approaches such as embryo treatments with hormones, heat shock, small molecules, or morpholinos. However, these methods have not been widely adopted by the industry due to high costs, challenges in integrating them into breeding programmes, or negative impacts on fish health and performance. Most critically, farming genetically engineered fish requires a failproof sterilisation strategy, which current non-genetic solutions are unable to provide," explains Lauth.

© CAT
The advantages of GE
The team at CAT are convinced that genome editing is the best option for inducing sterility, due to its combination of efficiency and efficacy.
“We've made a lot of progress using molecular and genetic tools to induce sterility, including using genome editing. This has been our choice and our team has come up with different strategies to create broodstock that can only produce completely sterile progeny,” notes Lauth.
“In general, you would likely prefer to have an animal functions normally in the hatchery, without extra steps or processes to create sterility. That is what we’re proposing using genome editing strategies: all progeny produced by edited broodstock, whether the broodstock are producing thousands or millions of eggs, would be completely sterile without intervention – achieved by using genome editing in the parents,” he adds.
How it’s done
Establishing a breeding programme for sterile animals sounds counterintuitive, but CAT have figured out two ways of achieving this.
“The biggest challenge was to figure out how to produce genetically sterile and monosex fish across multiple generations. Currently the most advanced approach – which is commercially available – involves using a surrogate parent. The other, which is still in the research phase, is to tap into key aspects of the way germ cells are formed in an embryo to create females that only produce sterile progeny, no matter what male they cross with. These are the two strategies we have exploited to mass produce sterile fish. And we have now successfully propagated these lines for at least four generations,” explains Plouffe.
Deciding which gene to knock out to have this effect varies from species to species, but the CAT team have been slowly building up their knowledge, making it easier for them to hit the target swiftly and the results are favourable.
“We’ve found that the sterile fish are healthy, behave like conventional fish but have an enhanced performance and better yield, showing that the energy is not diverted towards sexual maturation, but is instead allocated to somatic growth,” notes Plouffe, who adds that gene editing can be used to combine sterility with other traits.
“CAT has commercialised what we call Sterility+, with the ‘plus’ being traits desirable in a farmed environment. We’ve worked in this field for more than 12 years and using genome editing we've seen some remarkable increases, including a 30 percent increase in growth rates and a 10 percent improvement in feed conversion efficiency in our edited tilapia line, which can be realised within two generations. I think regular breeding programmes are happy if they achieve a 1 percent increase in food conversion efficiency per generation,” Lauth observes.
© CAT
Industry demand
CAT are working on making a wide range of aquatic species sterile and, according to Lauth, they’ve had a 100 percent strike rate with every finfish species they've tried so far.
“So across the finfish it's ready to go and we're open to further commercial partners,” notes Plouffe.
However, their main focus has been on species such as Atlantic salmon, where it could save the sector a significant sum of money. Indeed, according to Lauth, early maturation costs the sector half a billion dollars every year, as fish that mature early fetch much lower prices, due to their less appealing appearance and taste.
“From an impact perspective, we want to work with species that are commonly reared as I think you can have a larger impact there very quickly. But we're also aligning our work with those species and countries that are more permissive from a regulatory perspective,” notes Lauth.
As a result, tilapia is another strong candidate for CAT. Not only is it the second most cultured finfish group in the world, but CAT have also been working with the species for over 10 years.
“We know we can deliver this technology at commercial scale in tilapia,” Plouffe points out.
They also believe that marine pelagic finfish are worth prioritising, not least from a practical perspective.
“You need a lot of females in salmon, you need a lot of females in tilapia to do commercial production. But you don't need that many in marine pelagics, because each female produces so many eggs. That means fewer micro-injections are needed to produce the broodstock,” Plouffe observes.
CAT are also looking into crustaceans, especially vannamei shrimp.
“There's quite a bit of research being done in our facilities on shrimp at the moment and we've had some nice breakthroughs there this year just in terms of developing the tools, all the components necessary for commercial-scale operations.. How do you deliver the editing enzymes to shrimp embryos? How do you do that at scale? And then how do you rear the larvae and create the broodstock?” Plouffe notes.
Challenges
Despite the potential of genome editing, there are several major hurdles to overcome before fish that have been rendered sterile using this technology become a commercial possibility.
One of the biggest challenges relates to regulations , but – given that GE red sea bream are already produced and consumed commercially in Japan – there is a real sense of optimism that this will change.
“It depends on what country you're in. But we expect that over the next five years we'll start seeing quite a lot of changes about how genome edited products are regulated, particularly when there's no new DNA added, which is the solution that we have,” notes Plouffe
Cost is another key hurdle, but the team at CAT believe that genome editing delivers substantial returns on investment.
“We've demonstrated with our partners some really nice value models that show that the cost-benefit is definitely there, all the way along the value chain: from the producers to the processors,” notes Plouffe.
Despite all the clear advantages of producing sterile genome edited fish – notably the improved growth levels, the better robustness and the environmental advantages – there is still a challenge relating to enhancing social acceptance – both for genome editing as a process and for the products that it can help to provide. CAT are working on this, but are aware that they’ll need plenty of support.
“We are not going to be able to change the hearts and minds on our own, but we do think that every day there are more and more hearts and minds open to change and more people recognising the advantages. We need to consider how we, as the scientists, participate and how we transfer this knowledge to the producers. Because that's who the consumers trust, the consumers trust the farmers. So if the farmers can see the benefits and understand that this technology is safe, we can enrol some of those folks,” notes Lauth.
To illustrate his point Lauth refers to precedents in the medical sector where previously controversial technologies have now become mainstream.
“Initially in vitro fertilisation almost created rioting and yet today I think 2.5 percent of newborns in the US come from in vitro fertilisation and it’s completely accepted,” he concludes.







